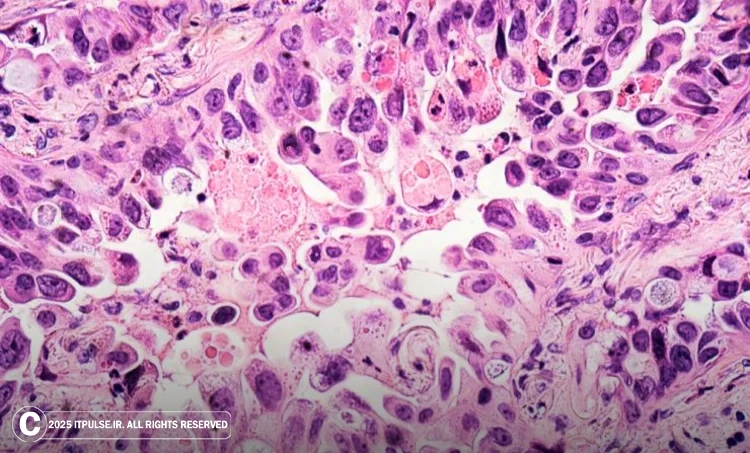

افزایش موارد سرطان ریه در افراد غیرسیگاری
سرطان ریه مدتهاست که با مصرف سیگار گره خورده، اما آمارهای جدید نشان میدهد تعداد زیادی از بیماران مبتلا به سرطان ریه، هیچگاه حتی یک نخ سیگار هم نکشیدهاند. این روند نگرانکننده، توجه بسیاری از پزشکان و پژوهشگران را به خود جلب کرده است. چرا کسانی که هرگز سیگار نکشیدهاند، به یکی از مرگبارترین انواع سرطان دچار میشوند؟
ماجرای مارتا، زنی ۵۹ ساله که هرگز سیگار نکشیده بود، نمونهای از همین پدیده است. او با علائم سادهای مانند سرفهی غیرمعمول و مخاط غلیظ به پزشک مراجعه کرد. ابتدا تصور بر این بود که مشکل او نوعی التهاب مزمن است، اما تصویربرداریهای دقیقتر، وجود یک لکه مشکوک را در ریهاش نشان داد. چند ماه بعد، با تشخیص نهایی «سرطان ریه مرحله سوم» مشخص شد که تومور به غدد لنفاوی اطراف نفوذ کرده است.
سرطان ریه در غیرسیگاریها: یک بیماری متفاوت
به گفته پزشکان، بین ۱۰ تا ۲۰ درصد از موارد سرطان ریه به افراد غیرسیگاری مربوط میشود. دکتر آندریاس ویکی، سرطانشناس از بیمارستان دانشگاه زوریخ، میگوید:
«سرطان ریه در غیرسیگاریها بیماریای مستقل با ویژگیهای مولکولی منحصربهفرد است. این تفاوتها تأثیر مستقیمی بر نوع درمان و شانس بهبود دارند.»
جالب اینکه افراد جوانی که به سرطان ریه دچار میشوند، بیشتر در گروه غیرسیگاریها قرار دارند. به گفته دکتر ویکی، وقتی بیماری با سن ۳۰ یا ۳۵ سال با این نوع سرطان مراجعه میکند، اغلب از غیرسیگاریهاست.
تفاوت در نوع سرطان: آدنوکارسینوم، نوع غالب در غیرسیگاریها
در گذشته، «کارسینوم سلول سنگفرشی» شایعترین نوع سرطان ریه بود؛ نوعی که معمولاً با مصرف سیگار در ارتباط است. اما در حال حاضر، آدنوکارسینوم، شایعترین نوع سرطان ریه در میان افراد غیرسیگاری به شمار میرود. این نوع از سلولهای تولیدکنندهی مخاط در ریه منشأ میگیرد.
آدنوکارسینوم نیز معمولاً در مراحل پیشرفته تشخیص داده میشود. تومورهای کوچکی که در بخشهای عمقی ریه پنهان هستند، تا زمانی که بزرگ نشوند یا به اندامهای دیگر گسترش نیابند، علائم واضحی ایجاد نمیکنند. سرفههای مداوم، درد قفسه سینه یا تنگی نفس، اغلب در مراحل پایانی دیده میشوند. همین موضوع باعث میشود سرطان ریه در افراد غیرسیگاری معمولاً در مرحله سوم یا چهارم تشخیص داده شود.
نقش ژنتیک و هورمونها؛ چرا زنان غیرسیگاری بیشتر در معرض خطرند؟
آمارها نشان میدهند زنان غیرسیگاری دو برابر بیشتر از مردان غیرسیگاری در معرض ابتلا به سرطان ریه هستند. یکی از دلایل اصلی این مسئله، جهشهای ژنتیکی خاصی است که در بدن برخی زنان بهویژه زنان آسیاییتبار وجود دارد. مهمترین این جهشها، EGFR نام دارد؛ ژنی که مسئول تولید پروتئینی به نام گیرنده فاکتور رشد اپیدرمی است.
سلولهای سرطانی در بدن افراد غیرسیگاری اغلب دارای مجموعهای از «جهشهای محرک» هستند. این جهشها مستقیماً باعث رشد غیرطبیعی سلولها میشوند. مطالعات نشان دادهاند که برخی از این جهشها با متابولیسم هورمون استروژن در ارتباط هستند؛ موضوعی که ممکن است علت شیوع بیشتر سرطان ریه با جهش EGFR در زنان را توضیح دهد.
داروهای هدفمند؛ امیدی تازه برای درمان سرطان ریه بدون سیگار
با شناسایی جهشهای محرک، داروهایی طراحی شدهاند که بهطور مستقیم فعالیت این پروتئینها را مهار میکنند. برای مثال، مهارکنندههای EGFR که حدود ۲۰ سال پیش عرضه شدند، توانستهاند پاسخ درمانی مثبتی در بیماران ایجاد کنند. البته اغلب بیماران پس از مدتی نسبت به این داروها مقاوم میشوند و تومورها دوباره بازمیگردند. با این حال، داروهای نسل جدید در دست توسعه هستند که میتوانند بر این مقاومت غلبه کنند.
امروز میانگین بقاء بیماران با جهشهای مشخص مانند EGFR به چندین سال رسیده است. پزشکان میگویند بیمارانی وجود دارند که بیش از ۱۰ سال است با کمک داروهای هدفمند تحت درمان هستند. این موفقیتها، نسبت به میانگین بقای کمتر از ۱۲ ماه در دو دهه پیش، تحولی چشمگیر محسوب میشود.
عوامل محیطی سرطان ریه در افراد غیرسیگاری
اگر سیگار عامل اصلی نباشد، پس چه چیزی باعث افزایش سرطان ریه در غیرسیگاریها میشود؟ مطالعات نشان دادهاند که برخی عوامل محیطی مانند دود دست دوم (استنشاق دود سیگار دیگران)، گاز رادون و آلودگی هوا از مهمترین علل این بیماری هستند.
همچنین استفاده از اجاقهای چوبی یا زغالی در محیطهای با تهویهی ضعیف، دود ناشی از پختوپز و آلودگی هوای داخل خانه، بهویژه در میان زنان خانهدار، به عنوان عوامل خطرزا شناسایی شدهاند. با این حال، آلودگی هوای بیرون از خانه یکی از مهمترین عوامل ابتلا به سرطان ریه در غیرسیگاریهاست.
ذرات معلق PM2.5؛ قاتلان نامرئی در هوا
یکی از خطرناکترین آلایندههای هوا، ذرات معلق PM2.5 هستند؛ ذراتی با قطری کمتر از ۲٫۵ میکرون که در دود ناشی از اگزوز خودروها و سوختهای فسیلی یافت میشوند. این ذرات میتوانند به عمق ریه نفوذ کرده و باعث التهاب، آسیب سلولی و در نهایت تحریک سلولهای جهشیافته شوند.
تحقیقات مؤسسه فرانسیس کریک در لندن نشان دادهاند که PM2.5 لزوماً باعث جهش ژنتیکی نمیشود؛ بلکه سلولهایی که از قبل دچار جهشهایی مانند EGFR شدهاند، را فعال میکند. این سلولها توسط سیستم ایمنی ریه، بهویژه ماکروفاژها شناسایی شده و با ترشح سیتوکینها (پیامرسانهای شیمیایی)، وارد فاز رشد و تقسیم میشوند.
نتیجهگیری: سرطان ریه بدون سیگار، تهدیدی نوظهور با پیچیدگی بالا
افزایش موارد سرطان ریه در افراد غیرسیگاری زنگ خطری است که نمیتوان آن را نادیده گرفت. این نوع سرطان نهتنها با عوامل محیطی مانند آلودگی هوا مرتبط است، بلکه به شدت تحت تأثیر ویژگیهای ژنتیکی و جنسیتی نیز قرار دارد. خوشبختانه با پیشرفت در درمانهای هدفمند و شناخت بهتر جهشهای مولکولی، امیدهای تازهای برای بیماران پدید آمده است.
اما همزمان باید به فکر پیشگیری نیز بود. کاهش آلایندههای هوا، بهبود تهویه در محیطهای بسته، اجتناب از دود دست دوم و آگاهیبخشی عمومی، گامهایی حیاتی برای محافظت از سلامت جامعهاند.

ارسال پاسخ